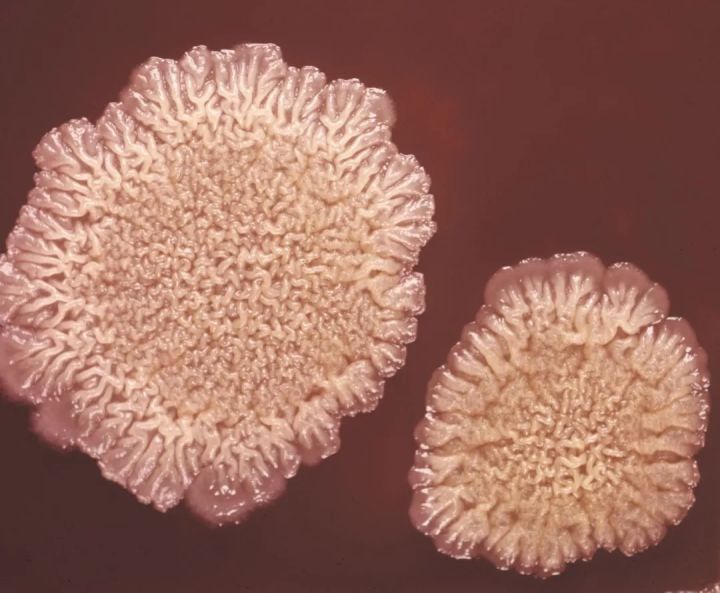

深度 | 网络、细菌与人口:比特币的命运


文 / New Bloc 基金经理 李福星
节点即价值
1993年,所有与美国国防部网络 ARPAnet 连接的电脑向 TCP/IP 协议转换,之后进入大规模商用。Internet 正式诞生。人类进入信息时代。
随着Internet发展,出现了网络三大定律: 摩尔定律 (Moore's Law) 揭示了硬件进步速度:IC上可容纳的晶体管数目,约每隔18个月便会增加一倍,性能也将提升一倍。这种在成本不变的情况下,计算机性能的不断提高。
吉尔德定律 (Gilder’s Law) 揭示了在路由传输介质影响之外,带宽主要受路由等硬件传输设备的运算速度和计算机运算速度的影响:在未来25年,主干网的带宽每6个月增长一倍,12个月增长两倍,即主干网带宽的增长速度至少是运算性能增长速度的三倍。 梅特卡夫定律 (Metcalfe's law) 侧重在网络的价值的描述:网络的价值与联网的用户数的平方成正比。摩尔定律描述的是技术发展的经济学规律:一个产品进入到大市场,单位利润会提高,同时技术进一步投入,价格大幅下降,市场进一步扩大,如此循环。梅特卡夫定律从宏观的社会和经济角度,为网络的价值估算提供了思路:对一个网络来说,用户数越多,每个人接触到的信息急速增加,那么整个网络和该网络内节点的价值也越大,吸引更多人加入,形成正反馈。最终网络的价值呈几何级数增长。同时,这一过程也使网络的使用费不断下降。 Network Value(t)=C*Nt2
C:价值系数;N:用户数量
好比一个人的人脉,认识的人越多,自己作为一个节点,就越有价值;如果认识另外一个“超级节点”,那么二者连接形成的价值会更大;如果网络里都是这种人,那么整个人脉网的价值不可估量。
学习也是一样,如果脑子里的知识点足够多,可以迅速进行连接,形成完善的思维模型,解决问题问题的能力就会大大提升,这就是价值。典型的网络,电话和手机是这样,汽车加油站是这样,阿里巴巴、支付宝、亚马逊、Windows系统、QQ微信微博等无不如此。当一项技术已建立必要的用户规模,它的价值将会突破临界点,呈爆炸性增长。去年,老罗做的“子弹短信”曾冲到了 App Store 免费榜第一,因为使用人数太少,网络没有足够多的节点,没有建立起生态,在短暂的闪光之后,像流星一样滑落。

- 资料来源:Outreaching Financial Inclusion With Cost-Cutting Innovation,Roberto Moro Visconti
节点的限制
对于Bitcoin这个网络,如何描述节点数量?首先,链上数据(地址数量、转账次数、全节点数、币龄)的质量和可靠度,远优于链下数据(交易所用户、钱包数等)。由于区块链的特性,我们可以很方便取得链上的数据,其中,最重要的衡量指标是 链上去重活跃地址数(Network Unique Addresses) 和 链上每日确认交易数(Transactions) ,这是该网络被使用情况的最基础、最准确的指标。

数据来源: https://coinmetrics.io 在比特币早期,仅限于少数几个 Cypherpunk 使用,就出现了1万比特币买俩大饼这种定价。10年后,比特币的 日转账金额已经达到100亿美元 这个级别, 日活跃地址达到100万 ,从华尔街的金融精英,到尼日利亚首都阿布贾郊区的年轻人,都在使用比特币,价格自然水涨船高了。当然,比特币的价值不仅因为使用人数、流动性溢价这些,更重要的是深层政经、社会学原因,是一个丰满的故事。10年来,比特币的历史就是一个传奇,它的成功曾经一度被严重夸大。但是,在音乐散去之后,不禁让人深思比特币的未来——这会一直指数式成长下去吗?好像不会。要知道,摩尔定律自1965年以来就是真理,但是半个世纪后,芯片晶体管和工作频率开始不再呈现指数式增长,摩尔定律开始成为历史了。

资料来源:The Future of Computing Performance (2011)
从网络价值、节点数量,到使用人数,使用人数的极限在哪?树不能长到天上去,不会真的 To Da Moon。我们从社会学和硬科学中寻找一点启发。
逻辑斯蒂曲线
我学习了一下人口增长模型。人口动力学中有个逻辑斯蒂增长模型 (Logistic growth model),表现了一个种群在有限环境中的连续增长情况。这种增长不是指数型的无线加速上涨,而是受制于有限的环境资源和自我抑制性,呈现S型的 Logistic 函数增长。

具体来说:在个体数很少的时候,种群数量增长缓慢;随个体数增加,数量快速增加,在数量达到饱和状态的一半时,增速最快;最后增速减缓,达到一个稳定的饱和状态。这就是一个简单的人口模型。人类社会大部分时间,都是资源限制着人口的增长。人类几十万年前就可以成功抵御天敌了,像没有天敌的动物一样,在本能驱使的 内禀增长能力 带来人口快速增加之后,主要靠不定期的 大规模死亡 (疾病、饥荒、战争)来实现“减少-恢复”周期。最近几个世纪,随着生产力的提高,人类对生存环境有预见性,为了避免饥饿、疾病和贫困,会主动节制生育,以 控制出生率 的方式,限制人口规模。所以,人口自然增长本来可以是无限的,但有文明以来,就不是无限自然增长的状态了。自然、经济、文化、政策、战争等因素,都影响着人口的增加。所有这些都包含了不确定性。要探索更本质的内在规律,需要对种群增长进一步抽象。这需要一个温度、湿度、光照和食物都理想的环境,且没有天敌。这需要在实验室条件下测量内禀增长率,寻找数学规律。
细菌的繁殖
生物学中有一个实验很有趣,这道题在高中生物考试中比较常见。这个实验是观察在纯粹的实验室培养基环境下细菌的繁殖情况。不考虑别的干扰项,就简单、原始、直接。
在这个实验中,把少量的单细胞微生物放置到干净的培养液里,在适宜的光照和温度条件下,定期取样,记录细菌数量的变化。最后,以细菌数量的对数为纵坐标,以时间为横坐标,绘制曲线。这就是 细菌生长曲线(Bacterial growth curve) 。简化一下,是这样:

资料来源:Encyclopædia Britannica, Inc.
最开始,细菌数量是Lag阶段,增加缓慢,因为初始的少量细菌对环境有个适应过程;在适应之后,细菌进入对数增长期,表现在对数坐标下是一条 稳定向上倾斜的直线 ;受制于培养基规模,环境资源逐渐被消耗,细菌数量进入一段稳定期;最后环境恶化,出现越来越多的死亡,数量下降。
这几乎是高度概括了人口发展曲线,仿佛就是一个中国朝代的人口指数、兴衰指数。 在一个不受限的环境中,没有达到饱和状态之前,种群的增长理论上是对数增长。 这个启发先记在这。
增长的轨迹
不管是理想环境下的细菌繁殖,还是人类种群,增长过程都是相似的。如果把这个模型概括一下,大概就是一条S型曲线,即Logistic函数曲线。之所以没有呈现出越来越快的指数型增长(J型增长),而是中间增长快两头缓慢的S型,一是受环境资源的限制,其次是自身调节机制。增长率不变的指数式增加,只存在于数学中。

种群的增长不可能不受种群自身密度变化的影响出现无限制增长;同理,一项新技术的增长,也必然受到市场占有率和人群总数的制约,呈现Logistic曲线。

数据来源:Growth and Dynamics of Populations,Kirsten Menking
我们都见过下面这个技术采用图。最近百年,以美国为例,新的技术发明被社会使用的进度有快有慢,冲水马桶普及用了100多年,彩电只用了24年。但是,这些技术普及的过程,全部呈现Logistic函数走势。

数据来源: https://ourworldindata.org
由细菌实验揭示的这一规律,清晰地呈现在人类新技术普及的过程中。
生命周期 与 炒作周期
这种新技术接受规律,进一步被归纳为 技术采用生命周期(Technology Adoption Life Cycle)。 (《跨越鸿沟》,杰弗里.摩尔)

Models for Predicting the Future: Geoffrey Moore’s “Crossing the Chasm”,Matt S. Smith
技术采用生命周期原本是一条钟形曲线,被分成5个组成部分,每个部分对应着一类群体。在技术诞生之初,2.5%富有冒险精神的创新者(innovators)开始探索,13.5%的早期采用者(Early Adopters)继续尝试,这两批人是早期的好奇宝宝。在好奇宝宝和主流大众之间,有一条“死亡鸿沟”(The Chasm),大部分新技术根本都迈不过去这条鸿沟,就在这里挂了。新技术继续被接纳,主流大众是在人群中占主体的早期大众(34%)和晚期大众(34%)。最后,技术得到普及/饱和,人群中还剩16%的落后者。
技术采用生命周期与Logistic曲线叠加,可以看出前者正好是从“速度”维度描述了Logistic曲线。

Gartner每年发布对新技术成熟度进行研究和分析的系列报告,其中的“ 炒作周期曲线 ”最为知名。在这个炒作周期中,可以对新兴技术的发展前景进行分析。

数据来源: https://www.gartner.com
曲线的编制原理很简单:将“炒作期望”和“技术成熟度”两个因素叠加。炒作剧烈影响着曲线的Y轴,来得又快又猛,短促的极端狂热中,大量注意力和资金被消耗,之后是漫长的低潮。技术成熟度如同股票的内在价值,像万有引力一样引导着市场预期,尤其是在长时间周期上。时间越长,炒作和预期就变得越温和,越贴近技术成熟程度。比特币诞生之后,商业可行性尚未被证伪,光环加身,在早期一些技术狂热分子鼓吹下,媒体正好有兴趣进行推波助澜,谈论此事成为一股潮流。在这种正反馈下,出现了很多被人们津津乐道的神话故事(10000比特币的“大饼”),新技术的成功迅速被夸大;区块链相关的初创公司开始一轮一轮融资,一拥而上,进入狂热的泡沫。这种看似“机遇”的繁荣,本质只是炒作推动的,基本面远远滞后于炒作预期。进入深水区后并不是很顺利,大家发现并没有出现想象中的场景,区块链技术商业应用的探索遭遇挫折,过高的期望没有被实际进展满足,负面报道涌出,无数企业现金流断裂,公众的兴趣也由盛转衰,炒作兴趣幻灭,批评铺天盖地,迅速滑入低谷,只有少数企业能够幸存。经过长时间的萧条,少数坚持下来的人渐渐有了突破,比特币本身的技术推陈出新(SegWit、闪电网络、隐私解决方案、Stratum V2、Schnorr 签名),带动相关产业萌发,主流人群开始渐渐接受;技术的成熟度强有力地推动着公众的认知,实际价值不断产生,预期被逐步实现。最终,相关应用开始复苏,智能合约、应用型token、证券型token百花齐放,市场不断扩大。Gartner在今年发布了区块链业务成熟度曲线( Hype Cycle for Blockchain Business),我们可以看到区块链技术在不同行业的发展情况。

数据来源: https://www.gartner.com
基于区块链的数据交换、智能资产、ACH支付、物联网、加密资产托管业务等,都处在萌芽期,鲜有实现落地。 加密资产托管 领域,华尔街的富达、Bakkt 已经开始试水,Crypto 世界的 Coinbase、Huobi 等也在开展,只是还没有得到大规模采用。难以大规模落地,是这两年大多数区块链项目濒临死亡的主要原因。
处在炒作上升期的有加密货币和区块链监管、智能合约、医疗、通信、供应链、物流、保险、教育、ZF区块链项目。这里面有些是已经初步落地的。去年8月,腾讯公司的 区块链电子发票 已经开始应用了,到今年底已经开出1000万张,算是成功落地。在泡沫破裂低谷的,有分布式账本、1C0、加密货币、交易所等。当前在熊市深处,谷底的这老几位最成功的区块链应用(俗称的“币圈”),都进入了低潮。和年头的鬼哭狼嚎相比,年尾的慢刀子割肉都感觉不到疼了。项目方跑路,交易所被盗,1C0被重拳猛揍,完全是数九寒冬之相。但是 这里面有金子的,很便宜的那种 。上述这两个曲线模型叠加,炒作周期中泡沫破裂的最底部,正对应着生命周期中的死亡之谷。这道坎,是一个新兴技术性命攸关的成年礼。

数据来源: https://www.gartner.com
我们关心的是, 比特币在哪个位置。
比特币已经安全运行了十一年,是一个大孩子了。虽然一路上“被夭折”数百次,但是在经历两轮牛熊之后,已顺利经度过了创新者时期。此刻,我相信,在Logistic曲线中, 比特币刚刚进入对数增长期 。2017年以来,比特币的影响力不断扩大:价格一度逼近20000美元,纽约证券交易所设立的Bakkt开张,嘉楠耘智在纳斯达克上市,我国强调把区块链作为重要突破口,各国有权有势的人频频提及比特币,Libra横空出世,DE/CP即将推出,华尔街开始建仓——这超出了密码学、互联网、金融, 已经成为一股全球性思想潮流 。我们似乎每天都能看到细碎的思想火花在夜空中四射。这两年,价格没有创新高,但是算力不断增加。同时,底层技术不断完善,媒体上曝光度、线下商家接受程度、千禧一代持有意愿大幅提升。世间才一日,密圈已三年。 比特币或许已经跨过“鸿沟”了,或许还没有。 绝大多数跨过不去的项目,是因为没有核心用户,也没有能落地的应用。这其中,唯一拥有核心用户、成功落地、且经受住了时间考验的,就是比特币。所以, 我们几乎可以确定它已经、或最终能跨过。 因为在这个动荡的世间——负的法定利率,负的无风险收益,过度负债的ZF,一轮一轮的货币宽松,掠夺性的政权,动荡的局势,局部冲突,战争,十数年一轮的金融危机—— 需求是确定的,只是主流大众需要一些时间和契机。
世界的尽头
比特币在悄悄地生长,尽头在哪里呢?从 供给 看,总量2100万枚,目前挖出了1836万枚,还有12.6%没被挖出,当前的年化通胀率3.6%;再过两天,“减半”之后,年化通胀率降为1.8%,低于黄金,也低于美联储给美元设定的2%。未来的产量相对于存量越来越小,稀缺度越来越突出。

数据来源: https://bitcoinvisuals.com
从 需求 看,UTXO Age Distribution显示越来越多的币被长期囤积起来,不再进入流通领域,未来可供使用的币日益稀少。这种通缩的影响力,将远大于挖矿产出来带的通胀。而使用比特币的人群,按照地址数(多个地址问题和交易所无钱包用户以抵消计算),在全球范围内仅有0.4%——要知道全球65%的人拥有手机,56%的人口使用互联网。

数据来源: https://plotly.com
从 体量 看,比特币还是小不点儿。当前1800亿美元的市值,是黄金的47分之一;离婚后的贝索斯身价有1430亿,几乎能全部买下;马云马化腾身价加起来770亿,合伙买能买一大半。个头很小,天花板很高。

数据来源: https://howmuch.net
顺便说一句,这不是光比特币的未来,这是 比特币们 的未来。2008金融危机中诞生的比特币,DNA 里面就嵌着对中心化货币的不信任,可“受任于败军之际,奉命于危难之间”,一生下来脑后就长着反骨。2011年,新东方老师李笑来初识比特币,立刻惊呼“ 此物一出天下反! ”(彼时大饼才2岁,所谓三岁看到老,先不提其他,李老师的这个认知,得服气。)比特币巧妙的设计,使其具有强大的反脆弱性。这两年,主要经济体的高层多次提及比特币,但是都没有动过打击的念头——非不为也,不能也。并且,“铁拳”每一次打击,都是一次中心化之恶的展示,是对比特币的正面宣传;全球性货币大放水,亚非拉多国恶性通胀,源源不断向比特币导流。未来,能送大饼上路的,只可能是加密货币内部的同志;到那个时候,我们不会怪他,把目光转向更优秀的标的,人们会做出选择。那个时候,我们只要起立,鼓掌,拥抱它就好了。
****************
本文仅为投资研究,本公司不会因任何人收到本文而视其为客户;在任何情况下,本文中信息或所表述的意见不构成对任何人的投资建议;在任何情况下,本公司不对任何人因使用本文内容所引起的损失负任何责任。
本文为「New Bloc研究」原创,如欲引用或转载本文内容,请注明出处。
市场有风险,投资需谨慎。
·
END
公众平台及联系方式
新浪微博 @NewBloc量化交易专家
英文电报 https://t.me/newbloc
官方推特 @bloc_new




